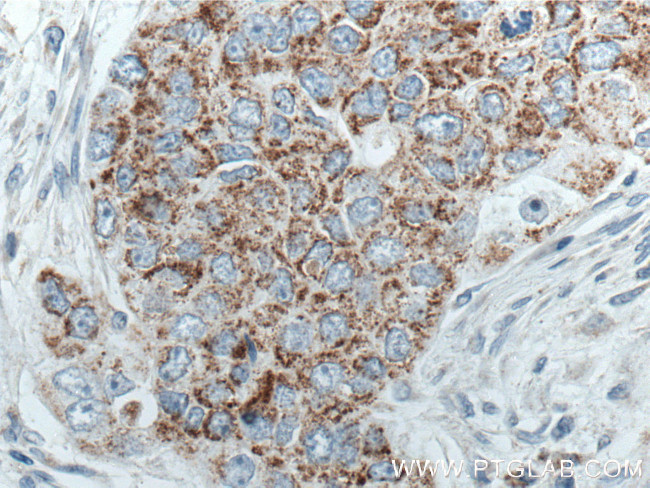
MRPL45 Antibody in Immunohistochemistry (Paraffin) (IHC (P))

Search
Proteintech
MRPL45 Monoclonal Antibody (1B4B4)
{{$productOrderCtrl.translations['antibody.pdp.commerceCard.promotion.promotions']}}
{{$productOrderCtrl.translations['antibody.pdp.commerceCard.promotion.viewpromo']}}
{{$productOrderCtrl.translations['antibody.pdp.commerceCard.promotion.promocode']}}: {{promo.promoCode}} {{promo.promoTitle}} {{promo.promoDescription}}. {{$productOrderCtrl.translations['antibody.pdp.commerceCard.promotion.learnmore']}}
产品信息
66531-1-IG
种属反应
宿主/亚型
分类
类型
克隆号
抗原
偶联物
形式
浓度
纯化类型
保存液
内含物
保存条件
运输条件
产品详细信息
Immunogen sequence: AGLVIPPEK SDRSIHLACT AGIFDAYVPP EGDARISSLS KEGLIERTER MKKTMASQVS IRRIKDYDAN FKIKDFPEKA KDIFIEAHLC LNNSDHDRLH TLVTEHCFPD MTWDIKYKTV RWSFVESLEP SHVVQVRCSS MMNQGNVYGQ ITVRMHTRQT LAIYDRFGRL MYGQEDVPKD VLEYVVFEKQ LTNPYGSWRM HTKIVPPWAP PKQPILKTVM IPGPQLKPEE EYEEAQGEAQ KPQLA (86-329 aa encoded by B C006235)
靶标信息
Mammalian mitochondrial ribosomal proteins are encoded by nuclear genes and help in protein synthesis within the mitochondrion. Mitochondrial ribosomes (mitoribosomes) consist of a small 28S subunit and a large 39S subunit. They have an estimated 75% protein to rRNA composition compared to prokaryotic ribosomes, where this ratio is reversed. Another difference between mammalian mitoribosomes and prokaryotic ribosomes is that the latter contain a 5S rRNA. Among different species, the proteins comprising the mitoribosome differ greatly in sequence, and sometimes in biochemical properties, which prevents easy recognition by sequence homology. This gene encodes a 39S subunit protein. Pseudogenes corresponding to this gene are found on chromosomes 2p and 17q.
仅用于科研。不用于诊断过程。未经明确授权不得转售。
篇参考文献 (0)
生物信息学
蛋白别名: 39S ribosomal protein L45, mitochondrial; L45mt; Large ribosomal subunit protein mL45; MGC11321; MRP-L45
基因别名: 2600005P05Rik; AU043542; L45mt; MRP-L45; Mrpl45; R75241
UniProt ID: (Mouse) Q9D0Q7
Entrez Gene ID: (Human) 84311, (Rat) 287656, (Mouse) 67036